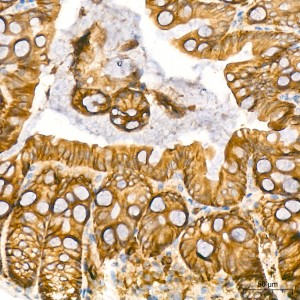
KO-Validated KRAS Rabbit mAb (20 μl)

| Reactivity: | Human, Mouse, Rat |
| Applications: | WB, IHC, ELISA |
| Host Species: | Rabbit |
| Isotype: | IgG |
| Clonality: | Monoclonal antibody |
| Gene Name: | KRAS proto-oncogene, GTPase |
| Gene Symbol: | KRAS |
| Synonyms: | NS; NS3; OES; CFC2; RALD; K-Ras; KRAS1; KRAS2; RASK2; KI-RAS; C-K-RAS; K-RAS2A; K-RAS2B; K-RAS4A; K-RAS4B; K-Ras 2; 'C-K-RAS; c-Ki-ras; c-Ki-ras2; AS |
| Gene ID: | 3845 |
| UniProt ID: | P01116 |
| Clone ID: | 9V5T1 |
| Immunogen: | Recombinant fusion protein containing a sequence corresponding to amino acids 1-188 of human KRAS (NP_203524.1). |
| Dilution: | WB 1:1000-1:2000; IHC 1:200-1:2000 |
| Purification Method: | Affinity purification |
| Concentration: | 1.23 mg/mL |
| Buffer: | PBS with 0.05% proclin300, 0.05% BSA, 50% glycerol, pH7.3. |
| Storage: | Store at -20°C. Avoid freeze / thaw cycles. |
| Documents: | Manual-KRAS monoclonal antibody |
Background
This gene, a Kirsten ras oncogene homolog from the mammalian ras gene family, encodes a protein that is a member of the small GTPase superfamily. A single amino acid substitution is responsible for an activating mutation. The transforming protein that results is implicated in various malignancies, including lung adenocarcinoma, mucinous adenoma, ductal carcinoma of the pancreas and colorectal carcinoma. Alternative splicing leads to variants encoding two isoforms that differ in the C-terminal region.
Images
 | Western blot analysis of various lysates, using KRAS Rabbit mAb (A23382) at 1:1000 dilution. Secondary antibody: HRP-conjugated Goat anti-Rabbit IgG (H+L) (AS014) at 1:10000 dilution. Lysates/proteins: 25μg per lane. Blocking buffer: 3% nonfat dry milk in TBST. Detection: ECL Enhanced Kit (RM00021). Exposure time: 45s. |
 | Western blot analysis of lysates from wild type (WT) and KRAS knockout (KO) 293T cells, using KRAS Rabbit mAb (A23382) at 1:1000 dilution. Secondary antibody: HRP-conjugated Goat anti-Rabbit IgG (H+L) (AS014) at 1:10000 dilution. Lysates/proteins: 25μg per lane. Blocking buffer: 3% nonfat dry milk in TBST. Detection: ECL Enhanced Kit (RM00021). Exposure time: 45s. |
 | Immunohistochemistry analysis of paraffin-embedded Mouse colon tissue using [KO Validated] KRAS Rabbit mAb (A23382) at a dilution of 1:200 (40x lens). High pressure antigen retrieval was performed with 0.01 M Tris-EDTA buffer (pH 9.0) prior to IHC staining. |
 | Immunohistochemistry analysis of paraffin-embedded Rat colon tissue using [KO Validated] KRAS Rabbit mAb (A23382) at a dilution of 1:200 (40x lens). High pressure antigen retrieval was performed with 0.01 M Tris-EDTA buffer (pH 9.0) prior to IHC staining. |
You may also be interested in: